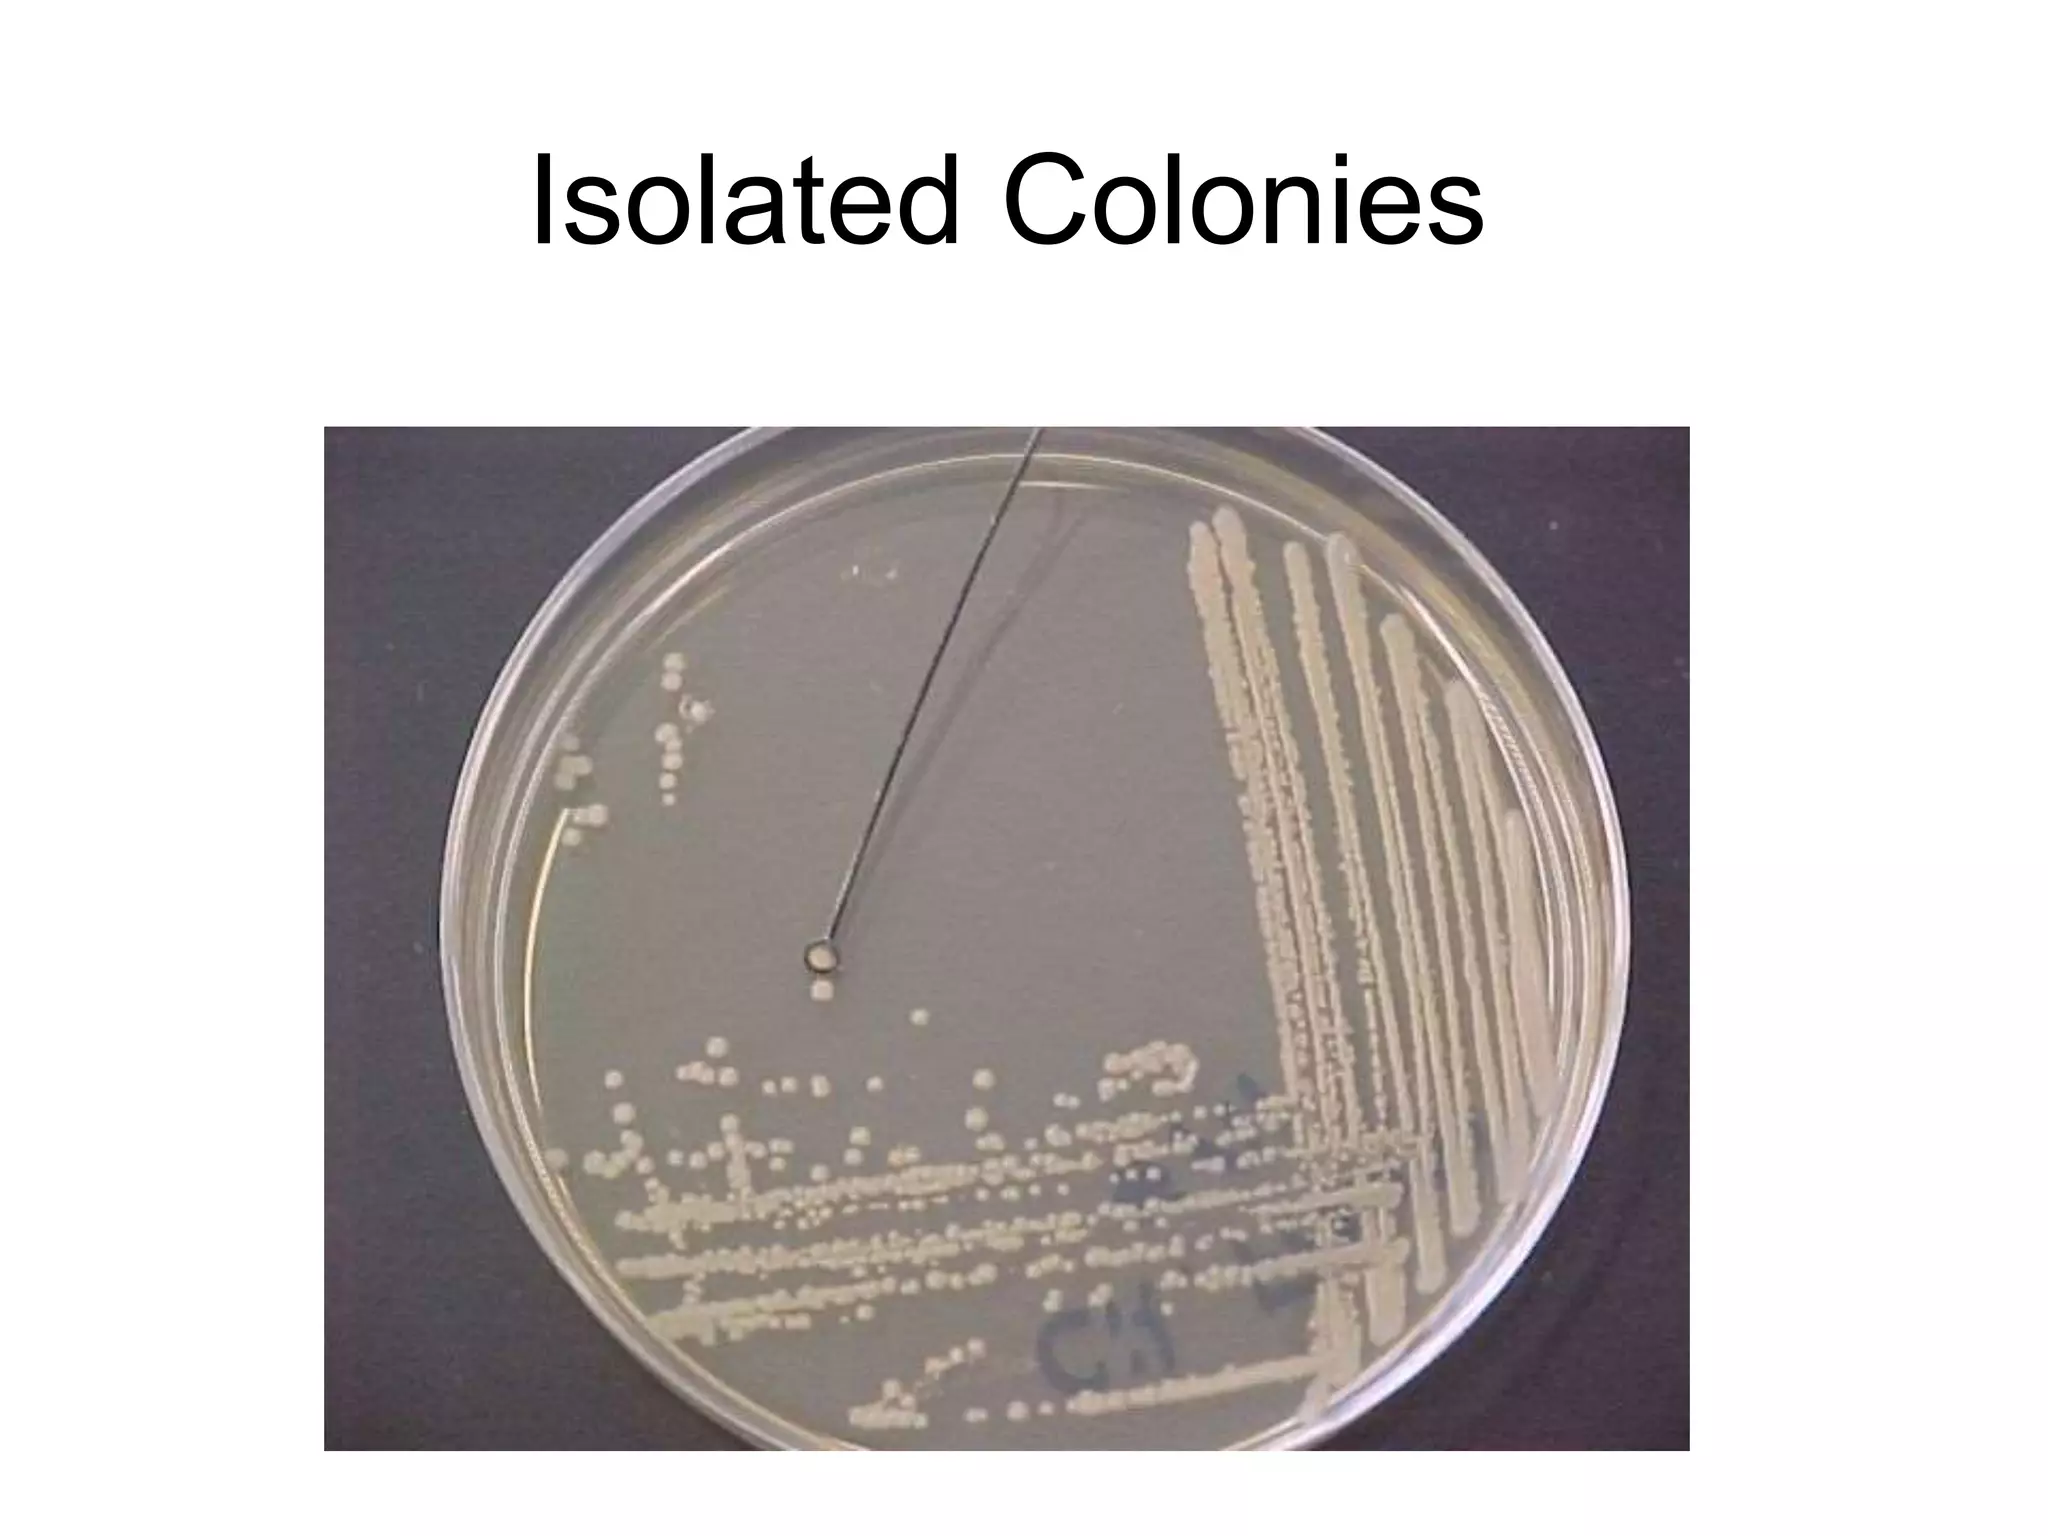
Isolated Colonies

Embed presentation
Downloaded 315 times
















This document discusses techniques for obtaining a pure culture from a mixed culture sample. It explains that a pure culture contains only one type of microorganism, while a mixed culture contains multiple types. The most common laboratory methods for isolating microbes are the streak plate method and pour plate method. Both rely on diluting bacterial cells to a point where single colonies can grow from individual cells. The streak plate method involves transferring a sample to an agar plate using a sterilized loop and streaking the inoculum in sections to separate individual colonies.